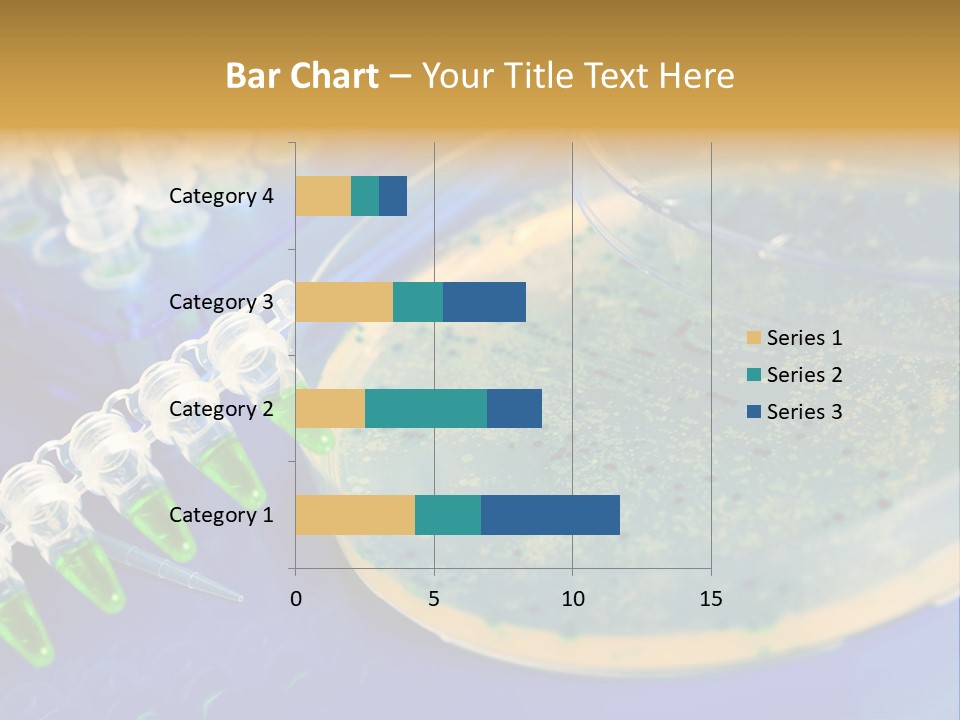
Holding Biochemistry Biotechnology PowerPoint Template
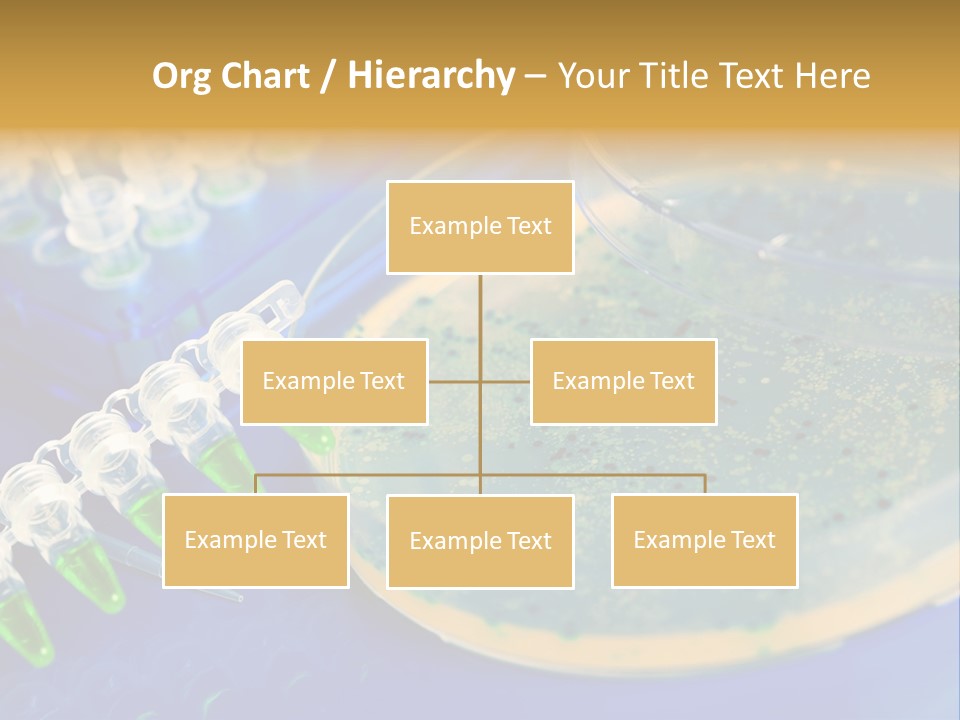
Holding Biochemistry Biotechnology PowerPoint Template
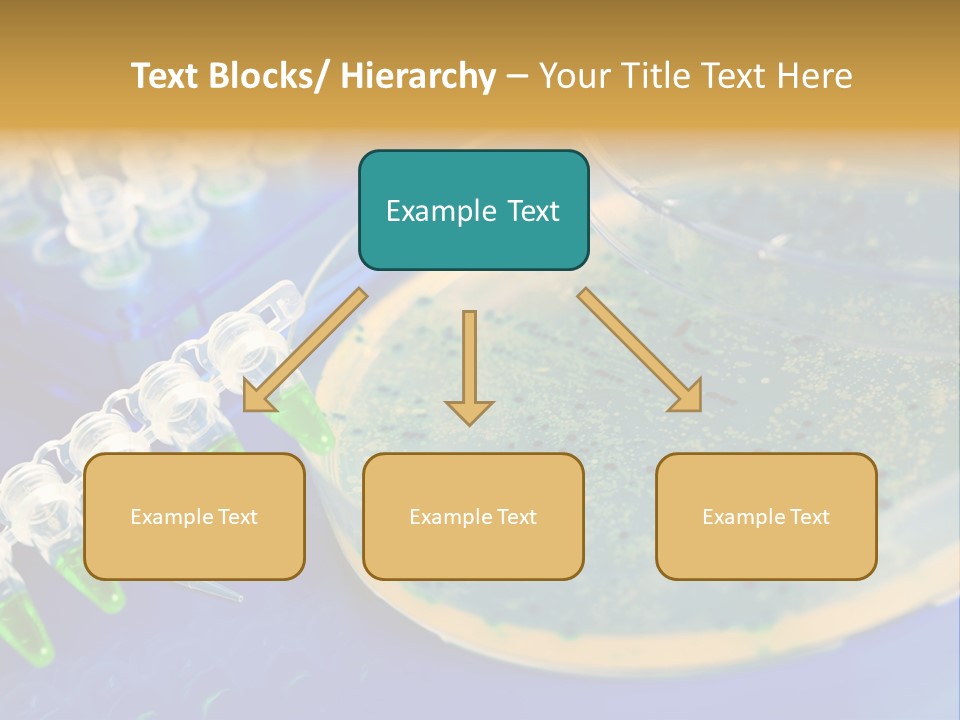
Holding Biochemistry Biotechnology PowerPoint Template
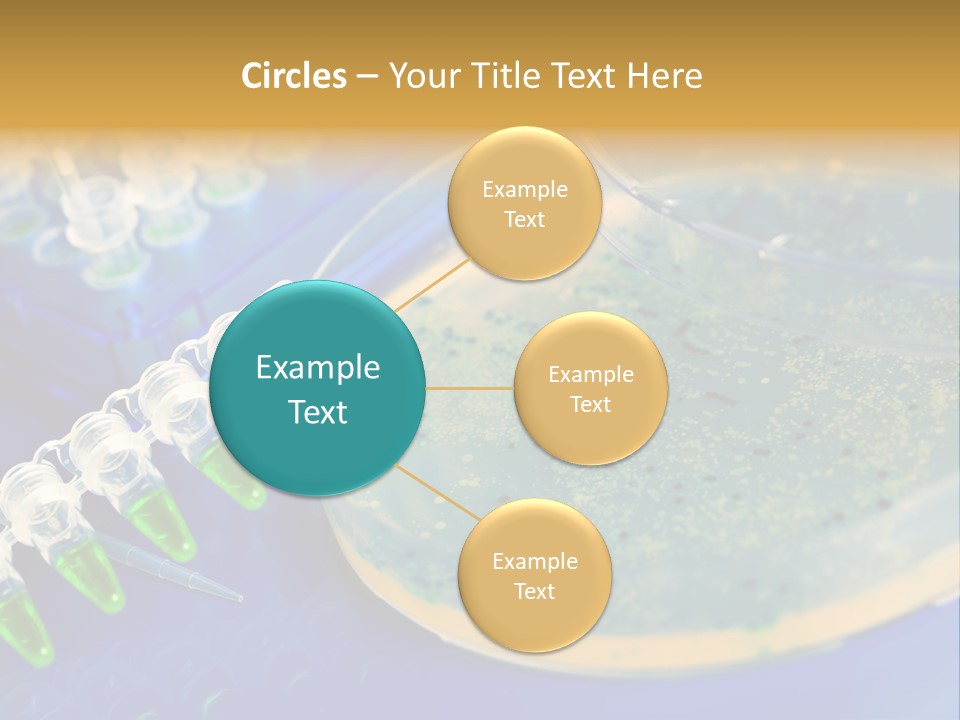
Holding Biochemistry Biotechnology PowerPoint Template
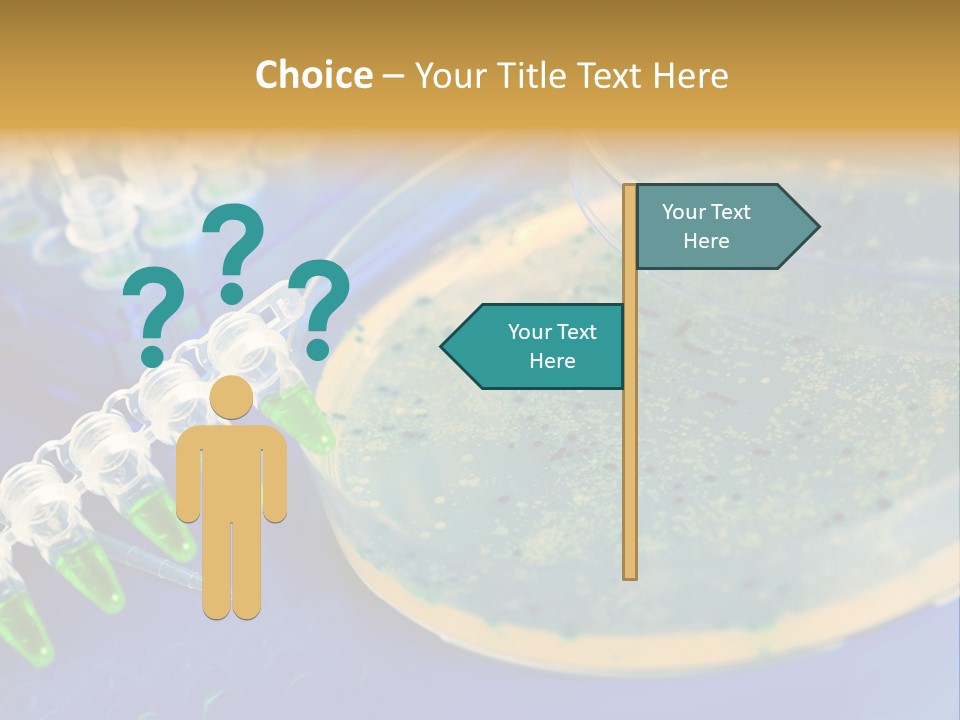
Holding Biochemistry Biotechnology PowerPoint Template
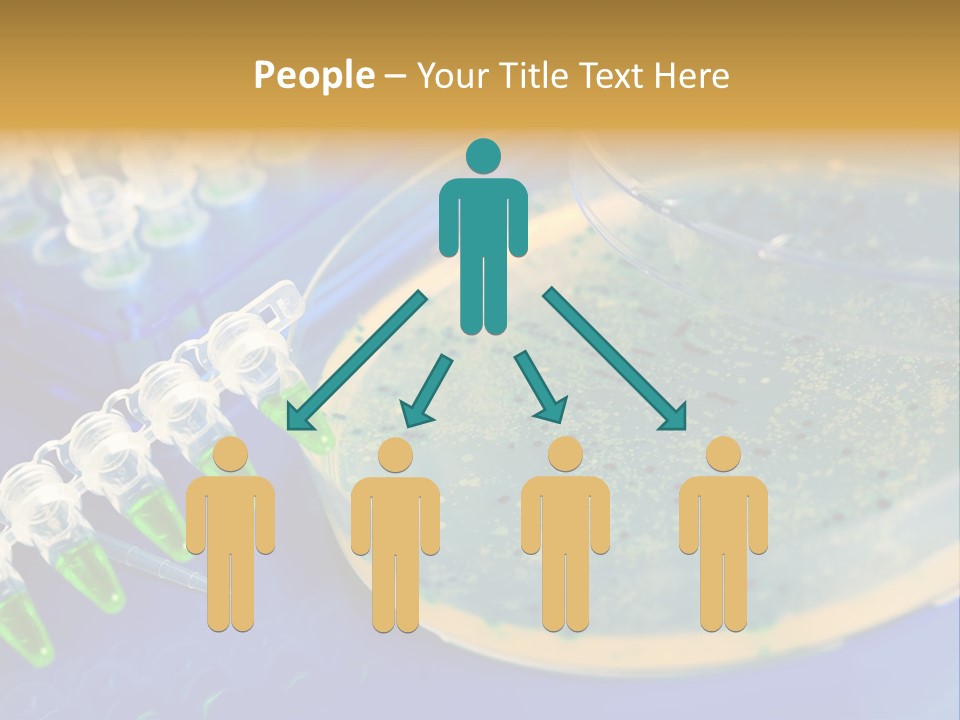
Holding Biochemistry Biotechnology PowerPoint Template
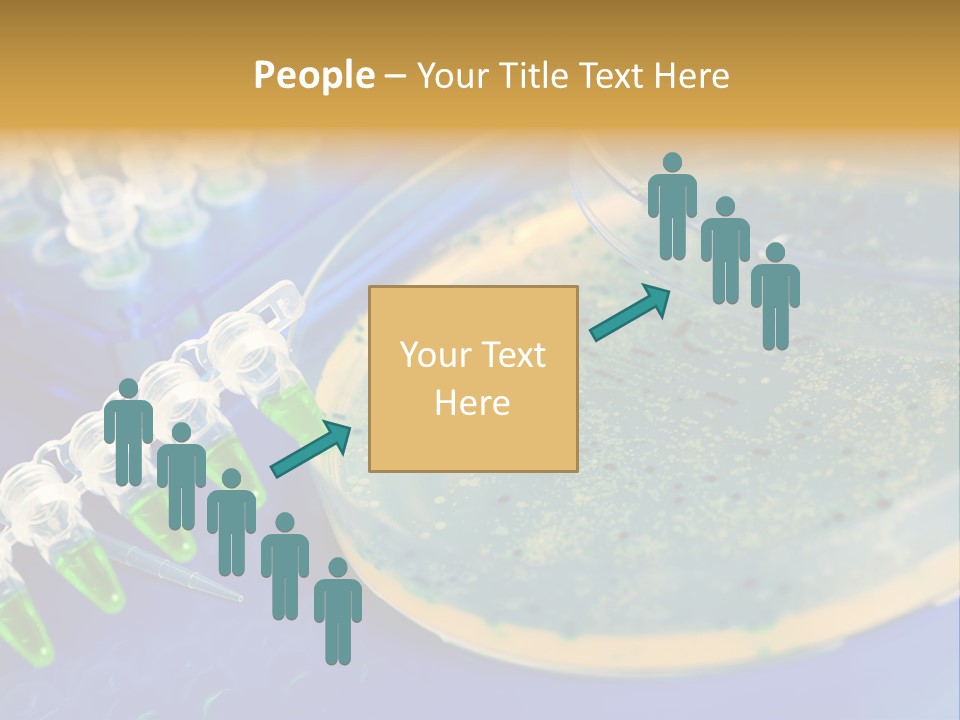
Holding Biochemistry Biotechnology PowerPoint Template

Holding Biochemistry Biotechnology PowerPoint Template
ID: PPT-0000138812
Standard Stock-Templates License
Free for personal and commercial use with attribution required.
Free
3 slides
Free
90 slides
-
Slides:
3 or 90 Slides
-
Compatible with:
Microsoft PowerPoint, Google Slides, Apache OpenOffice, Apple Keynote
-
Aspect Ratio:
1024x768
4:3 @ 96 dpi (Normal),
16:9 (Widescreen) -
File Type:
PPT, PPTX
-
File Size:
1.51 MB - 1.83 MB
-
Download File Type:
ZIP
-
Created:
May 13, 2017
liquid
water
light
blue
azure
fluid
solution
gas
engineering
electric blue
font
drink
science
solvent
glass
circle
transparent material
macro photography
mineral water
drinking water
drinkware
circuit component
chemistry
research
plastic
laboratory equipment
electronic engineering
light bulb
metal
electronic component
pattern
optoelectronics